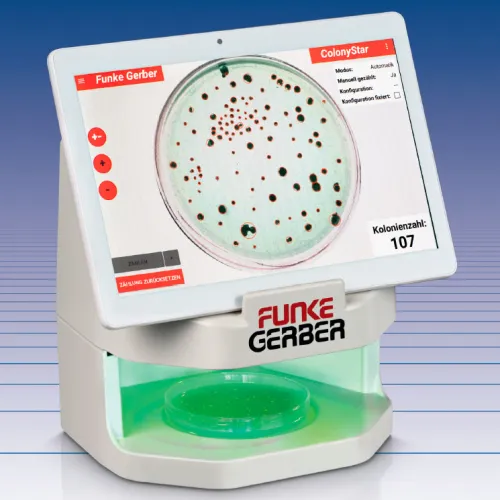

Гарантия от производителя
Счетчик колоний Funke-Gerber ColonyStar automatic со стандартным планшетом (Артикул 8550)
- Производитель: Funke-Gerber
- Код Товара: 15514-06
По запросу
-
+
Счетчик колоний Funke-Gerber ColonyStar automatic оснащен камерой и беспроводным экраном для быстрой и легкой оценки количества колоний микроорганизмов в чашке Петри.
Счетчик колоний поддерживает три режима работы:
1. Ручной режим.
Колония будет отмечена и подсчитана при нажатии на выбранную колонию. Это действие можно отменить, нажав еще раз на ту же колонию.
2. Режим помощи.
В диалоге с устройством можно быстро и легко оценить количество колоний в чашке Петри, то есть колонии одного типа автоматически записываются, отмечаются и подсчитываются при нажатии на одну колонию.
3. Автоматический режим.
Устройство «обучается» с помощью нескольких чашек Петри, а затем может оценивать аналогичные чашки Петри за секунды, «полностью автоматически». Устройство обеспечивает хранение и сортировку результатов, включая исследованные изображения.
В комплект поставки счетчика колоний Funke-Gerber ColonyStar automatic входят сканер ColonyStar и планшетный компьютер со стандартными характеристиками.
Технические характеристики счетчика колоний Funke-Gerber ColonyStar automatic:
Электропитание сканера счетчика колоний: 100 - 240 В, 50 - 60 Гц
Макс. мощность сканера счетчика колоний: 14 Вт
Диагональ экран планшета: 10“ (254 мм)
Операционная система планшета: Android
Класс защиты: II
Тип защиты: IP20
Рабочая температура: 5 °C - + 40 °C
Температура хранения: -10 °C - + 60 °C
Размеры (сканер ColonyStar) (ДxШxВ): 186 x 155 x 197 мм
Вес (сканер ColonyStar + планшет): 1665 г
Счетчик колоний поддерживает три режима работы:
1. Ручной режим.
Колония будет отмечена и подсчитана при нажатии на выбранную колонию. Это действие можно отменить, нажав еще раз на ту же колонию.
2. Режим помощи.
В диалоге с устройством можно быстро и легко оценить количество колоний в чашке Петри, то есть колонии одного типа автоматически записываются, отмечаются и подсчитываются при нажатии на одну колонию.
3. Автоматический режим.
Устройство «обучается» с помощью нескольких чашек Петри, а затем может оценивать аналогичные чашки Петри за секунды, «полностью автоматически». Устройство обеспечивает хранение и сортировку результатов, включая исследованные изображения.
В комплект поставки счетчика колоний Funke-Gerber ColonyStar automatic входят сканер ColonyStar и планшетный компьютер со стандартными характеристиками.
Технические характеристики счетчика колоний Funke-Gerber ColonyStar automatic:
Электропитание сканера счетчика колоний: 100 - 240 В, 50 - 60 Гц
Макс. мощность сканера счетчика колоний: 14 Вт
Диагональ экран планшета: 10“ (254 мм)
Операционная система планшета: Android
Класс защиты: II
Тип защиты: IP20
Рабочая температура: 5 °C - + 40 °C
Температура хранения: -10 °C - + 60 °C
Размеры (сканер ColonyStar) (ДxШxВ): 186 x 155 x 197 мм
Вес (сканер ColonyStar + планшет): 1665 г
Большой выбор оборудования
Быстрая качественная доставка
Индивидуальный подход